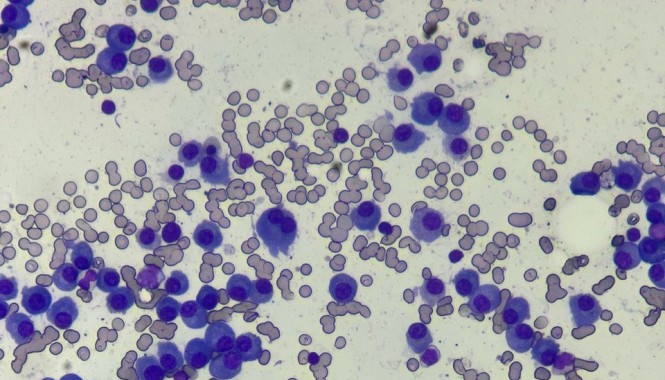
Март – месяц борьбы с множественной миеломой (миеломной болезнью)

26 марта — Международный день действий против множественной миеломы
Этот день во всем мире традиционно завершает месяц борьбы с множественной миеломой — периода, когда врачи, пациенты и их семьи объединяют усилия для повышения информированности и развития ранней диагностики этого заболевания. Множественная миелома — второй по распространённости вид рака крови. По оценкам международных исследований, ежегодно во всём мире выявляется более 176 000 новых случаев.
Почему важна осведомленность
Осведомленность об этом заболевании очень важна, потому что:
- 70% заболевших имеют такие симптомы, как усталость, рецидивирующие инфекции, боли в костях, одышка, анемия, что часто воспринимаются как следствие хронического стресса или переутомления;
- в настоящее время это онкологическое заболевание успешно лечится, если вовремя поставлен диагноз.
Что такое множественная миелома
Множественная миелома — это злокачественное заболевание системы крови, связанное с неконтролируемым разрастанием плазматических клеток в костном мозге. Патологический процесс приводит поражению костной ткани (к патологическим переломам), к снижению иммунитета, развитию анемии, а также к «сгущению» крови вследствие выработки патологических белков и склеивании эритроцитов, в так называемые «монетные столбики», представленные на нашем фото.
Ранняя диагностика спасает жизни! Берегите себя и своих близких — вовремя обращайтесь к врачу!
Рекомендованные обследования
Запишитесь на приём
Гематолог 2 700 — 3 900 ₽